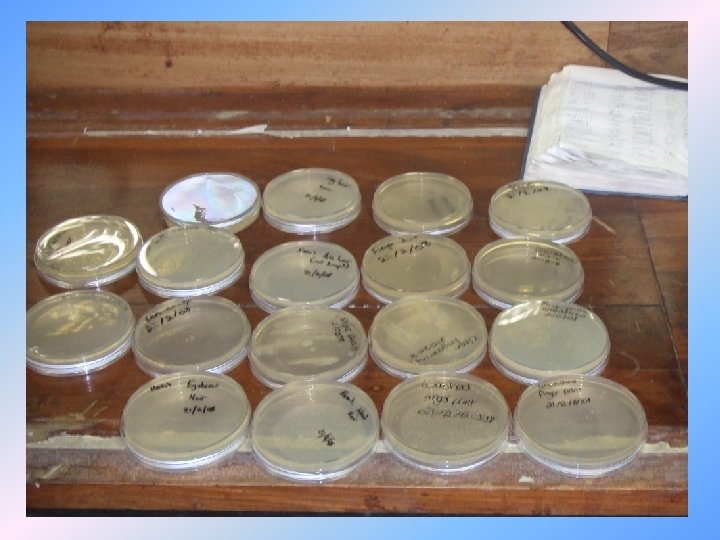

22a65c1ba7b60a3dc7847cabe1c8211f.ppt
- Количество слайдов: 20

Presentation » Presented by Orlaith, Dearbhaile, Kevin (big) and Kevin (little)

Introduction In our presentation today we hope to: • Give you an insight into a Leaving Certificate experiment which we carried out while on campus. • The different machinery which we were introduced to. • Investigation of Miscanthus • A tour of the University’s facilities. • An insight into the benefits we got out of this experience.

The Production and analysis of ethanal. Monday, 18 th of February, we prepared analysed a sample of ethanal. We performed this under the title: The preparation of ethanal and the investigation of the reaction products. This experiment was of great help to us as it is on our leaving certificate course in chemistry. It also taught us some fundamental skills a chemist should have. • • We learned to dispense weights and volumes of chemicals. Identify the safety precautions in use while handling chemicals. Assemble a quickfit reaction and distillation apparatus. In analysis we learned to use some analytical instrumentation: Gas chromatography. High performance liquid chromatographic (HPLC) analysis. UV- visible spectroscopy Fourier Transform Infra Red Spectroscopy.

The preparation of ethanal. Ethanal as a chemical, (also known as aldehyde- CH 3 CHO) has many uses in pharmaceuticals and the world around us. It can be found in many substances, such as alcoholic beverages. We will further speak of the applications and uses of ethanal 1. Set up apparatus as in diagram. 2. Surround the conical flask with ice in a large beaker. 3. Heat the dilute acid until it boils and then turn off heat. 4. Slowly, add alcohol mixture from the dropping funnel so as to maintain a gentle boiling. (the ethanal distils off as its formed. ) 5. Redistil the impure ethanal and collect the fraction boiling between 20 and 23 degrees Celsius.

Analytical Instrumentation After producing the ethanal we used a number of different instrumentations to analyse it. They were: -Ultra Violet-Visible (UV-VIS) spectroscopic analysis. -Infra Red (IR) spectroscopic analysis. -High Performance Liquid Chromatography (HPLC) analysis. -Gas Chromatography (GC) analysis.

Ultra Violet-Visible (UV-VIS) spectroscopic analysis. • We placed a cuvette of water into the machine as our control sample. • The results on the graph showed that water absorbs no light. • We then placed a cuvette of ethanal into the machine and our results read that ethanal absorbs light between a spectrum of 200700 nano meters. . Therefore the colour of a substance is determined by the colours it absorbs and reflects.

-Infra Red (IR) spectroscopic analysis. • What is Infra Red Spectroscopic analysis? • It’s a method of analysis in which the bonds present in a substance are detected, a graph is plotted and you compare it with a key which allows you to identify the bonds. • This machinery can be used in a variety of industries such as the Grain Industry.

High Performance Liquid Chromatography (HPLC) analysis. We participated in a lab With 2 nd year Environmental Science students who used the HPLC to determine the amount of caffeine in three substances (coffee, tea and coca-cola). We used a known concentration of caffeine and used the results to determine the unknown amounts in the other substances. Industry use HPLC to determine the Different amount of substances Within their products such as the Pharmaceutical and Beverages industries.

Gas Chromatography (GC) analysis. In the lab with the Environmental Students we also used the GC to Determine the different percentages Alcohol in beverages. We used a test substance (ethanol) Along with another substance (propanol) at different strengths And injected samples into the GC. We then injected the test subjects (wine, lager and beer) into the GC. We determined the percentages Of the test subjects by comparing the Spikes of the ethanol and propanol. We inputted the information in the Computer and got a plotted as our result.

Miscanthus as a Bio fuel • Miscanthus, or more commonly known as “elephnat grasses” is native to Japan and India. It gets its name “elephant grass” because you could hide an elephant in it, according to David Attenborough. Miscanthus to be produced as a bio fuel. However a long maturing process must be undertakin to reach maximum organic matter ratio. This process usually takes four years to achieve, in our climate

Calorific value of Miscanthus • This procedure we took a one gram of the test specimen, which was miscanthus and tested in the instrument Leo likes to call “The bomb”. We basically took a dried sample of the material and combusted it in a oxygen filled “bomb”. It was placed in a bath of water and the temperature of the water was recorded before and after the bomb was ignited. These results were then put in a formula and we were able to calculate the calorific value

Miscanthus Vs Petrol/Diesel • In order to achieve bio fuels replacing Petrol/diesel 70, 000 hectares must be given to produce willow and miscanthus farms (in Ireland alone). Farmers do get given grants for undertaking this “ecofriendly” solution, but is it realistic that farmers will give up on tillage and dairy crops?

Observations I made • When checking are test piece after the Calorific test, we were told that nothing should remain in the crucible. However I observed a black soot contained in the bomb itself. This would lead me to believe the with this form of fuel in engines that it will clog up the interior design shorting the life span of the engine

University’s facilities -While on work experience at the University we got an opportunity to experience some of the facilities that UL offers. -While partaking in labs we got to experience not only high tec machines that we wouldn’t have previously seen but also student life. We found the students extremely friendly and willing as they answered any questions put to them. -On Tuesday morning we got the unique opportunity to visit the state of the art Health Science Building. We were all extremely pleased at this as we got to experience the new footbridge and some of us had a great time jumping on it!!!! -On Wednesday afternoon we were extremely grateful to get a tour of the Glucksman Library and especially to the Librarian Michelle Breen who was extremely helpful and provided us with information and research methods which we could use for this presentation.

The UL Experience.

REMEMBER: Chicken “waste” is the fuel of the future!!!!!!!
22a65c1ba7b60a3dc7847cabe1c8211f.ppt